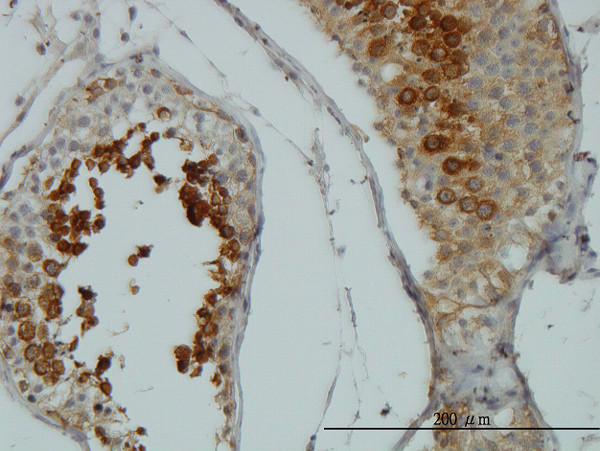
AKT1 Antibody in Immunohistochemistry (Paraffin) (IHC (P))

Search
Abnova
AKT1 Monoclonal Antibody (6G6)
{{$productOrderCtrl.translations['antibody.pdp.commerceCard.promotion.promotions']}}
{{$productOrderCtrl.translations['antibody.pdp.commerceCard.promotion.viewpromo']}}
{{$productOrderCtrl.translations['antibody.pdp.commerceCard.promotion.promocode']}}: {{promo.promoCode}} {{promo.promoTitle}} {{promo.promoDescription}}. {{$productOrderCtrl.translations['antibody.pdp.commerceCard.promotion.learnmore']}}
产品信息
H00000207-M05
宿主/亚型
分类
类型
克隆号
抗原
偶联物
形式
浓度
规格
保存条件
运输条件
产品详细信息
Sequence of this protein is as follows: MSDVAIVKEG WLHKRGEYIK TWRPRYFLLK NDGTFIGYKE RPQDVDQREA PLNNFSVAQC QLMKTERPRP NTFIIRCLQW TTVIERTLHV ETPEEREEWT TAIQTVADGL KKQEEEEMDF RSGSPSDNSG AEEMEVSLAK PKHRVTMNEF EYLKLLGKGT FGKVILVKEK ATGRYYAMKI LKKEVIVAKD EVAHTLTENR VLQNSRHPFL TALKYSFQTH DRLCFVMEYA NGGELFFHLS RERVFSEDRA RFYGAEIVSA LDYLHSEKNV VYRDLKLENL MLDKDGHIKI TDFGLCKEGI KDGATMKTFC GTPEYLAPEV LEDNDYGRAV DWWGLGVVMY EMMCGRLPFY NQDHEKLFEL ILMEEIRFPR TLGPEAKSLL SGLLKKDPKQ RLGGGSEDAK EIMQHRFFAG IVWQHVYEKK LSPPFKPQVT SETDTRYFDE EFTAQMITIT PPDQDDSMEC VDSERRPHFP QFSYSASGTA
靶标信息
AKT1 (PKB alpha) is a serine/threonine kinase that regulates cell survival. The activated enzyme inhibits apoptosis and stimulates cell cycle progression by phosphorylating numerous targets in various cell types, including cancer cells. This protein kinase is activated by insulin, PI3K, IGF1 and various other growth and survival factors. Akt promotes cell survival by inhibiting apoptosis through phosphorylation and inactivation of several targets, including forkhead transcription factors, and caspase-9. The AKT pathway is a major target for cancer drug discovery.
仅用于科研。不用于诊断过程。未经明确授权不得转售。